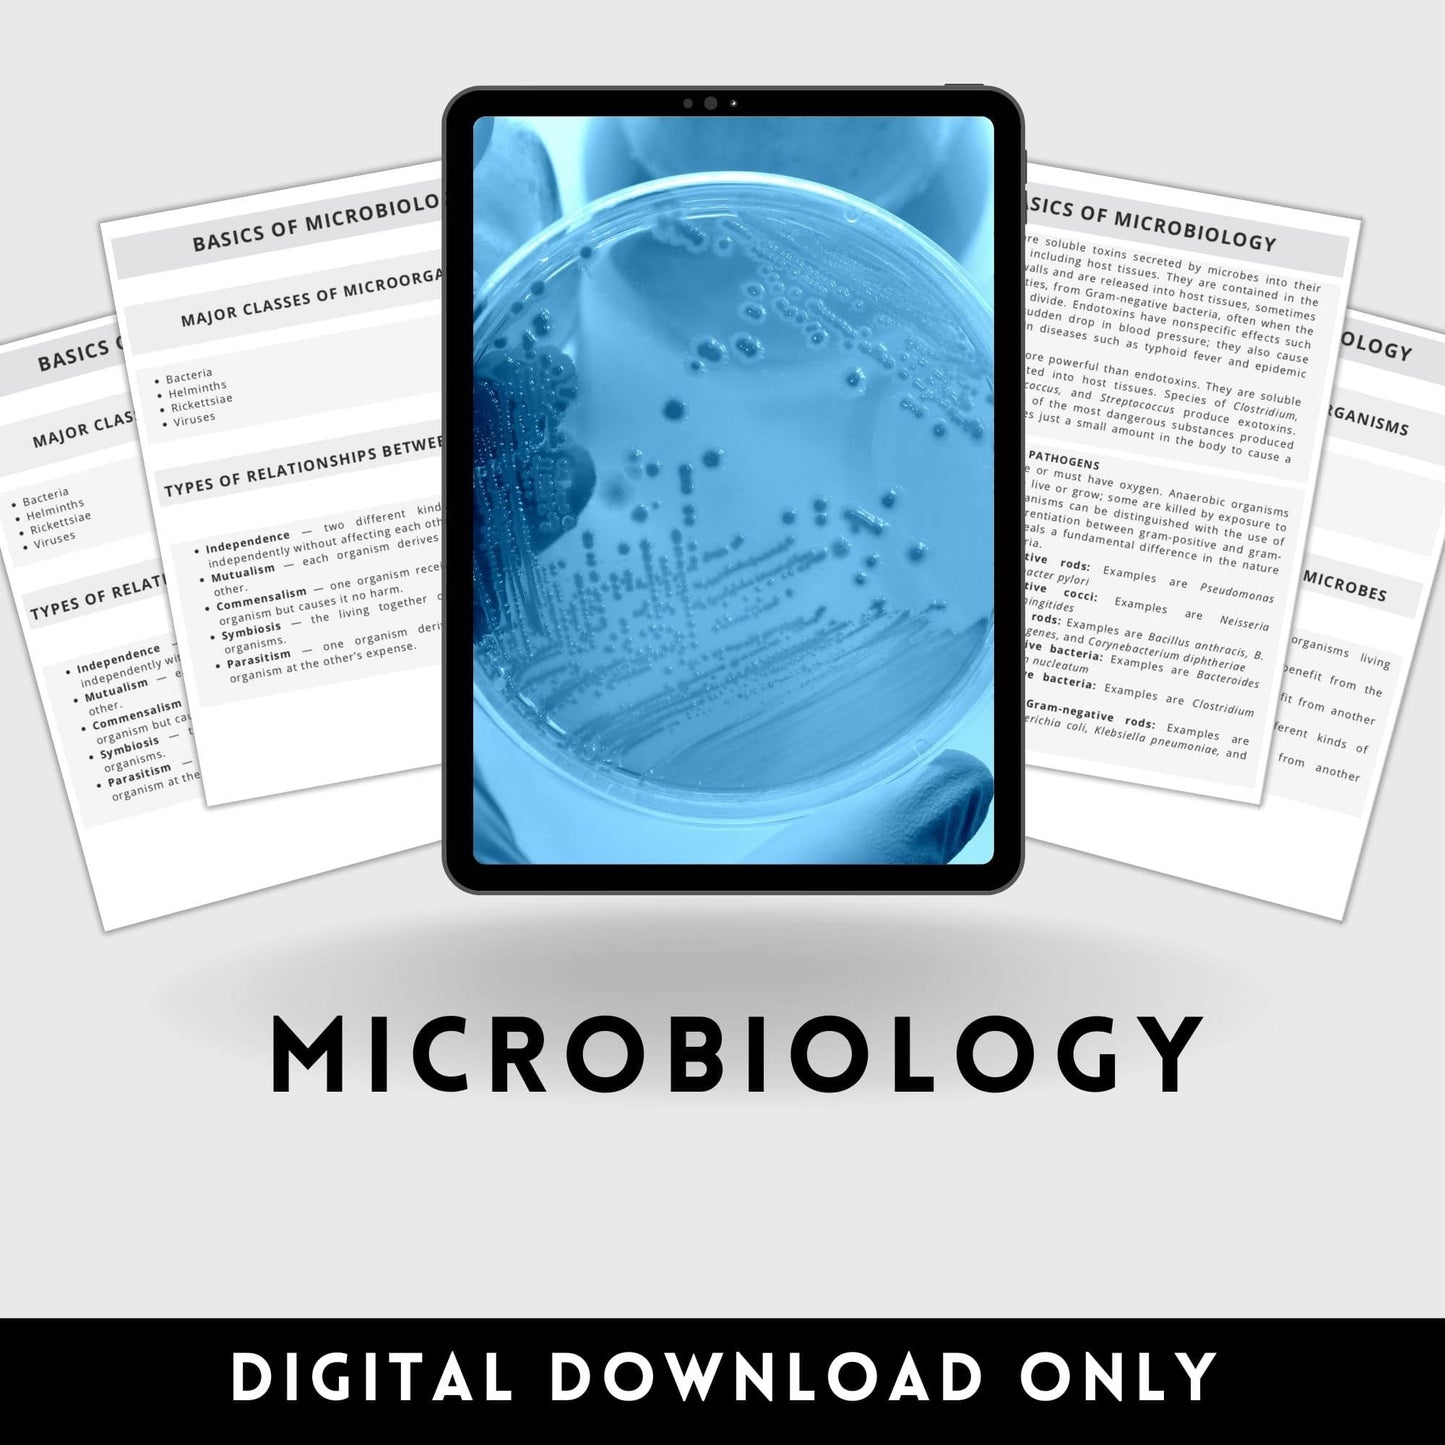

Artsyclinicalguide
Surgical Microbiology
Surgical Microbiology
Couldn't load pickup availability
♡ This item is a digital download and no physical item will be shipped to you. Enjoy instant Access to your study guides.♡
Concise notes for Surgical students and professionals to study on the go. Created to help you keep info fresh in your mind for clinical, sterile tech, CST, NBSTSA and NCCT certification exams
6 page study guide pdf download surgical microbiology study guide
Artsy Clinical Guide Store is devoted to making studying less time consuming and accessible to everyone.
** This is an instant download PDF file. Once you check out, you’ll receive a download link. No physical items**
Get your value Bundle.
Share
Usage license?
Usage license?
Individual License Only- All items listed in Artsy Clinical Guide Store are strictly for personal, non-commercial use only. Your order cannot be shared (even for free), resold, redistributed, or used for any commercial purposes. No redistribution allowed. Personalized customer watermark is applied upon download on each pdf. Unauthorized distribution will lead to account termination & legal action. Each purchase is for ONE user only. Institutions require a separate license.
Institutional license usage -Our product license is for individual use only and does not permit redistribution to students, staff, or multiple users within an organization. Please contact us at support@artsyclinicalguide.com or use the contact form to discuss licensing options tailored to your institution’s needs. Pricing varies based on the number of users and intended usage. Unauthorized distribution or use beyond an individual license violates our terms of service. Each Products are watermarked to individual accounts, and monitored for unauthorized distribution. Institutions found in violation may result in revocation of access without a refund and subjected to immediate legal action. If you require multiple users to use the product, an institutional license is required. Read
Exactly what happens after I purchase this?
Exactly what happens after I purchase this?
After you checkout you will see a link to immediately download the guide. Your order arrives as a digital download file, so get ready to download files to your device and pop them open for use. If you’re having trouble downloading or have any questions immediately reach out to us. For the bundles you will be getting a Zip file, to unzip them double click on the file after download it should reveal the contents within the folder.
**Please note no items will be shipped to you. This is an instant digital download only***
Do you offer refunds or cancellations?
Do you offer refunds or cancellations?
Due to the nature of the products, all downloads are final sale, unless there is omission of information or errors discovered, in which case we will issue a full refund. No exchanges.
Claims deemed an error on our part are covered at our expense. That's why we offer a 7-day no-hassle refund for any issues of omission or errors of information, in which case we will issue a full refund.
Can I cancel my order after confirming and get a full refund?
No! We don't offer refund for people who cancel their orders, only for reasonable reasons. No cancellation is possible to due to the nature of the product being available for immediate downloads.
If you are not satisfied, for any reason, let us know. We’ll work with you to make sure you’re happy.
To read the full terms and conditions of your purchase, please click here.
You can always contact us for any question at support@artsyclinicalguide.com
Does it work with all devices?
Does it work with all devices?
All downloadable items are provided in PDF format, which can be accessed on most devices, including desktops, tablets, and mobile phones. However, the initial download must be completed on a desktop device. For bundles, you will receive a ZIP file—simply double-click the file after downloading to extract its contents. Please note that all digital files are watermarked and linked to individual user accounts to prevent unauthorized sharing or distribution. Unauthorized redistribution may result in access revocation and legal penalties.
How can I get some help?
How can I get some help?
Great! Simply email support@artsyclinicalguide.com or send us a message on “contact us” page at the bottom of the screen. Someone from the team will be in touch within 24 hours.
What if your notes don’t help me?
What if your notes don’t help me?
We get it, sometimes things don't work out. We always aim to make sure our customers love our products. Our no hassle 7-day happiness policy means that if you are not satisfied, for any reason, we’ll work with you to make sure you’re happy, even if that means a full refund.
Can I cancel my order and get a refund?
Can I cancel my order and get a refund?
No! We don't offer refund for cancelled orders due to the nature of the product.

Bundle And Save
TONS of confused and freaked-out students have transformed their grades.
Melissa R. - "The flash cards were awesome. The cards were simple and clear, it saved me so much time."